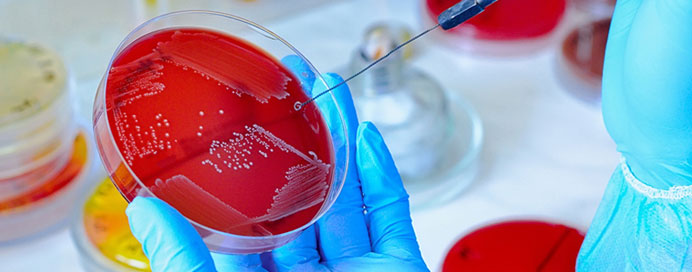

The Microbiology & Serology Department specializes in the detection, identification, and monitoring of infectious diseases caused by bacteria, viruses, fungi, and parasites.
Through advanced testing methods, it helps determine the exact cause of infection and guides doctors in selecting the most effective treatment.
Serological tests also detect antibodies and antigens in the blood, assisting in diagnosing viral infections and evaluating the body’s immune response.
 Comprehensive Infection Diagnosis – Detection of bacterial, viral, fungal, and parasitic infections through advanced testing.
Comprehensive Infection Diagnosis – Detection of bacterial, viral, fungal, and parasitic infections through advanced testing. Serological Screening – Identification of antibodies and antigens for diseases like HIV, Hepatitis, Dengue, and Typhoid.
Serological Screening – Identification of antibodies and antigens for diseases like HIV, Hepatitis, Dengue, and Typhoid. Culture & Sensitivity Tests – Determines the causative organism and effective antibiotic treatment plan.
Culture & Sensitivity Tests – Determines the causative organism and effective antibiotic treatment plan. Automated & Reliable Technology – Performed using modern microbiological systems for high precision.
Automated & Reliable Technology – Performed using modern microbiological systems for high precision. Strict Quality and Safety Standards – Ensures sterile handling, accurate testing, and dependable results.
Strict Quality and Safety Standards – Ensures sterile handling, accurate testing, and dependable results. Expert Pathologists & Technicians – Skilled professionals ensure quick, verified, and clinically relevant reports.
Expert Pathologists & Technicians – Skilled professionals ensure quick, verified, and clinically relevant reports.